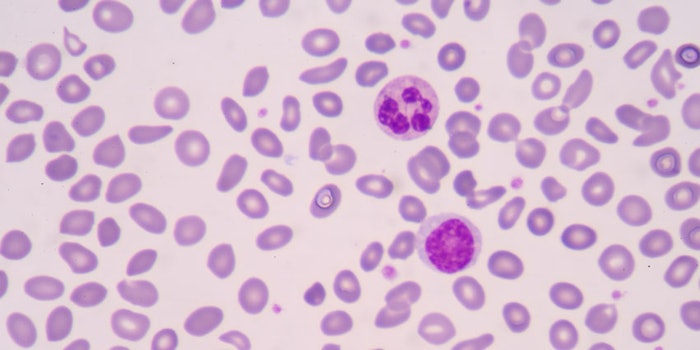
manvsmachineskincancerstudy_np

A competition between man and machine occurred to see if the programmed machine called convolutional neural networks (CNN) was able to detect signs of melanoma better than skilled dermatologists. A team from Germany, the United States and France taught the machine how to distinguish between benign and dangerous skin lesions, and the results were published in the Journal Annals of Oncology.
Man Vs. Machine Study
Dermascopic images and corresponding diagnoses were used to train and validate CNN. The cross-sectional reader study featured 100 image-based tests that had a level one and a level two test. The level one test only consisted of dermoscopy images, and the level two test combined dermoscopy with clinical information and images, tests.
There were 58 dermatologists that tested against the machine; these dermatologist came from 17 different countries with 51% of them being considered experts, i.e. more than five years of experience, and 29% being beginners, i.e. less than two years of experience.
So Who Won?
For the level one testing, the dermatologist scored a mean of 86.6% when tested on their detection of the sensitivity of the lesions and 71.3% on specificity for lesion classification. However, when the dermatologist were provided with more information in the level two testing their performance percentage increased to 88.9% and 75.7% on sensitivity and specificity, respectively.
The CNN performed better than the dermatologists on the specificity test for both level one and two with a percentage of 82.5%. Overall, most dermatologists were outperformed by the CNN, so they may benefit from assistance by the CNN's image classification.